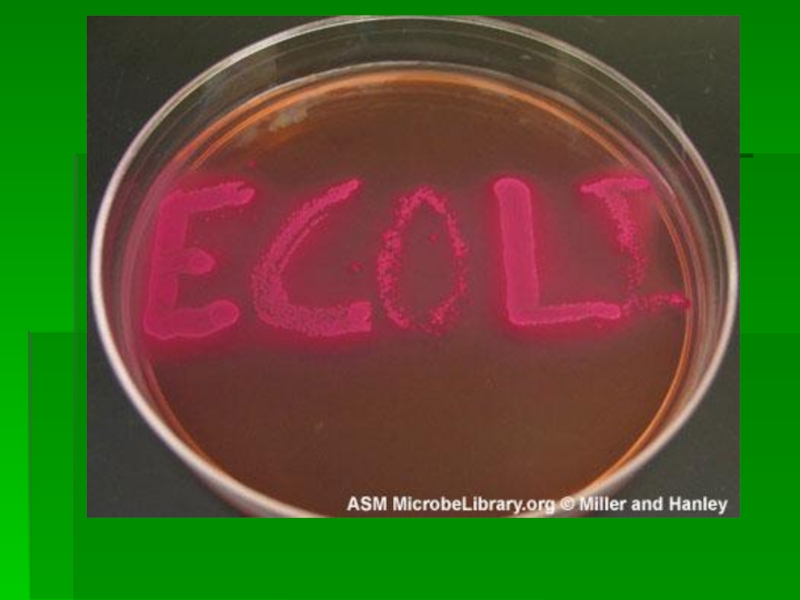

- Главная
- Разное
- Образование
- Спорт
- Естествознание
- Природоведение
- Религиоведение
- Французский язык
- Черчение
- Английский язык
- Астрономия
- Алгебра
- Биология
- География
- Геометрия
- Детские презентации
- Информатика
- История
- Литература
- Математика
- Музыка
- МХК
- Немецкий язык
- ОБЖ
- Обществознание
- Окружающий мир
- Педагогика
- Русский язык
- Технология
- Физика
- Философия
- Химия
- Шаблоны, фоны, картинки для презентаций
- Экология
- Экономика
Презентация, доклад по биологии Бактерии E.Coli
Содержание
- 1. Презентация по биологии Бактерии E.Coli
- 2. РОД ЭШЕРИХИЯESHERICHIA
- 3. Эшерихия была выделена немецким педиатром Т. Эшерихом
- 4. Классификация До 1984г. Числился всего 1 вид
- 5. 2. E.coli (неактивный) – включает метаболически инертные
- 6. МорфологияЭшерихии мелкие Гр- прямые палочки размерами 1-1,5
- 7. Растут при температуре от 15 до 45
- 8. Слайд 8
- 9. Слайд 9
- 10. Культуральные свойства Образуют разные типы колоний:1.
- 11. Колонии E.coli на МПА
- 12. Слайд 12
- 13. До 40-х годов прошлого столетия эшерихии считались
- 14. Появилась возможность сравнить по антигенам энтеропатогенные кишечные
- 15. Ведущий тип передачи пищевой (особенно через молоко
- 16. Внекишечная патологияКроме этого Эшерихии частые возбудители инфекций
- 17. Лабораторная диагностика ЭПКП Материал: испражнения,
- 18. Материал не должен превышать 1/3 объема транспортной
- 19. Слайд 19
- 20. Благодарю за внимание!
РОД ЭШЕРИХИЯESHERICHIA
Слайд 3Эшерихия была выделена немецким педиатром Т. Эшерихом в 1886 г. из
фекалий здоровых детей и взрослых.
Эшерих назвал ее – Bacterium coli communis - кишечная палочка
В 1953 г. этим м/о присвоили название ESHERICHIA
С1958 г. Род является типовым родом семейства Энтеробактерий
Эшерих назвал ее – Bacterium coli communis - кишечная палочка
В 1953 г. этим м/о присвоили название ESHERICHIA
С1958 г. Род является типовым родом семейства Энтеробактерий
Слайд 4Классификация
До 1984г. Числился всего 1 вид E. coli
В последнем
определителе 6 видов, из которых у человека встречаются 5:
1. E. coli - один из основных представителей нормальной микрофлоры кишечника человека и животных;
- включает ЭПКП (энтеропатогенные клинические патогены), вызывающие ОКЗ (острые кишечные инфекции) -эшерихиозы.
1. E. coli - один из основных представителей нормальной микрофлоры кишечника человека и животных;
- включает ЭПКП (энтеропатогенные клинические патогены), вызывающие ОКЗ (острые кишечные инфекции) -эшерихиозы.
Слайд 52. E.coli (неактивный) – включает метаболически инертные штаммы, которые трудно отличить
от шигелл (неподвижные, не образующие газ при ферментации глюкозы, лактозоотри- цательные)
3. E fergusonii (1985 г.)
4. E hermanii (1982 г.)
5. E vulneris (1982 г.) – эти 3 вида выделяются редко, в осн. при раневой инфекции.
3. E fergusonii (1985 г.)
4. E hermanii (1982 г.)
5. E vulneris (1982 г.) – эти 3 вида выделяются редко, в осн. при раневой инфекции.
Слайд 6Морфология
Эшерихии мелкие Гр- прямые палочки размерами 1-1,5 х 2-5 мкм.
Могут иметь
капсулу или микрокапсулу
В основном подвижны, но имеются неподвижные штаммы.
В мазках располагаются одиночно или парами
В основном подвижны, но имеются неподвижные штаммы.
В мазках располагаются одиночно или парами
Слайд 7Растут при температуре от 15 до 45 градусов. Оптимальная Т –
37. При 60 градусах погибают за 10 мин.
Оптимальная рН 7,2-7,4
В окружающей среде (почве, воде) выживают около месяца, на предметах – до 10 дней.
Оптимальная рН 7,2-7,4
В окружающей среде (почве, воде) выживают около месяца, на предметах – до 10 дней.
Слайд 10Культуральные свойства
Образуют разные типы колоний:
1. Круглые влажные, выпуклые колонии,
размерами 3 мм
2. Слизистые колонии, напоминающие клебсиеллы
3. Мелкие колонии (1-2мм), напоминающие шигеллы
4. Плоские, сухие колонии, с неровным краем колонии (не вирулентны)
2. Слизистые колонии, напоминающие клебсиеллы
3. Мелкие колонии (1-2мм), напоминающие шигеллы
4. Плоские, сухие колонии, с неровным краем колонии (не вирулентны)
Слайд 13До 40-х годов прошлого столетия эшерихии считались абсолютно безопасными обитателями кишечника.
К середине 50-х годов накопились многочисленные сведения о том, что некоторые штаммы эшерихий могут вызывать острые кишечные инфекции
В 1949-50 гг. датский микробиолог Кауфман создал схему типирования эшерихий по поверхностным антигенам.
Слайд 14Появилась возможность сравнить по антигенам энтеропатогенные кишечные палочки, которые выделялись в
различных регионах.
По морфологическим, биохимическим и культуральным свойствам энтеропатогенные кишечные палочки от нормальных не отличаются.
Отличаются только по наличию определенных поверхностных антигенов.
По морфологическим, биохимическим и культуральным свойствам энтеропатогенные кишечные палочки от нормальных не отличаются.
Отличаются только по наличию определенных поверхностных антигенов.
Слайд 15Ведущий тип передачи пищевой (особенно через молоко и молочные продукты). Второй
по значению путь – водный (в жарких странах).
Эшерихиозы распространены в основном в жарких странах с низким уровнем санитарной культуры. В Европейских странах умеренного пояса коли-инфекции встречаются редко. Для жителей Западной Европы, Канады и США эшерихиозы входят в группу основных возбудителей «диареи путешественников».
Эшерихиозы распространены в основном в жарких странах с низким уровнем санитарной культуры. В Европейских странах умеренного пояса коли-инфекции встречаются редко. Для жителей Западной Европы, Канады и США эшерихиозы входят в группу основных возбудителей «диареи путешественников».
Слайд 16Внекишечная патология
Кроме этого Эшерихии частые возбудители инфекций мочевых путей (до 50
%) О1,О4,О6, О16; желчного пузыря, могут вызывать респираторные инфекции, отиты, раневую инфекцию, менингит О2, О6,О7 и сепсис
Слайд 17Лабораторная диагностика ЭПКП
Материал: испражнения, рвотные массы.
Испражнения собирают сразу
после дефекации (при наличии слизи и гноя их надо включать в отбираемую пробу), доставляют в лабораторию не позднее, чем через 2 часа.
Если нет возможности доставить материал сразу, можно использовать транспортную смесь (консервант) – глицериновую смесь.
Если нет возможности доставить материал сразу, можно использовать транспортную смесь (консервант) – глицериновую смесь.
Слайд 18Материал не должен превышать 1/3 объема транспортной смеси
Если материал отбирают ректальными
тампонами, то использование транспортной смеси обязательно.
Материал, помещенный в консервант сохраняют до начала исследования при Т 4-6 градусов
Рвотные массы отбирают в стерильные банки (50 мл), нейтрализуют 10 % раствором натрия бикарбоната, доставляют в течение 2 часов.
Материал, помещенный в консервант сохраняют до начала исследования при Т 4-6 градусов
Рвотные массы отбирают в стерильные банки (50 мл), нейтрализуют 10 % раствором натрия бикарбоната, доставляют в течение 2 часов.